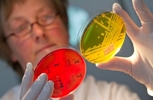

Суспільство
Підписуйтесь на Житомир.info в Telegram
У Житомирській області ускладнилася ситуація із захворюваністю на кишкові інфекції, - Центр здоров’я